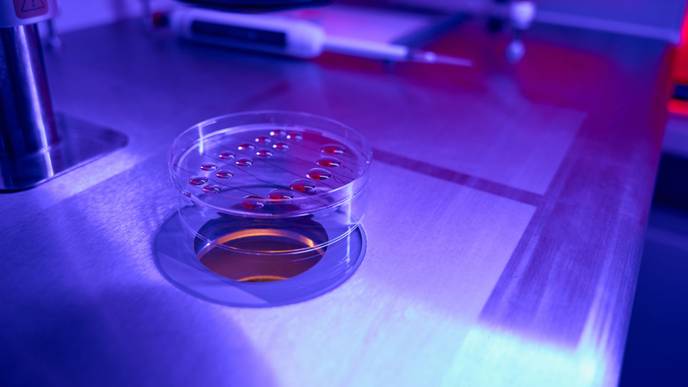
ReachMD Healthcare Image

Mitochondrial Disruption Shortens Telomeres in Mouse Cells
02/21/2024
"[...] our findings provide a preliminary understanding of how mitochondrial and telomeric aging mechanisms may interact to accelerate reproductive and somatic aging."
BUFFALO, NY- February 21, 2024 – A new research paper was published in Aging (listed by MEDLINE/PubMed as "Aging (Albany NY)" and "Aging-US" by Web of Science) Volume 16, Issue 3, entitled, "Disruption of mitochondrial unfolded protein response results in telomere shortening in mouse oocytes and somatic cells."
Caseinolytic peptidase P (CLPP) plays a central role in mitochondrial unfolded protein response (mtUPR) by promoting the breakdown of misfolded proteins and setting in motion a cascade of reactions to re-establish protein homeostasis. Global germline deletion of Clpp in mice results in female infertility and accelerated follicular depletion. Telomeres are tandem repeats of 5'-TTAGGG-3' sequences found at the ends of the chromosomes. Telomeres are essential for maintaining chromosome stability during somatic cell division and their shortening is associated with cellular senescence and aging.
In this new study, researchers Mauro Cozzolino, Yagmur Ergun, Emma Ristori, Akanksha Garg, Gizem Imamoglu, and Emre Seli from Yale School of Medicine, IVIRMA Global Research Alliance and Imperial College London asked whether the infertility and ovarian aging phenotype caused by global germline deletion of Clpp is associated with somatic aging, and tested telomere length in tissues of young and aging mice.
"In this study, we asked whether the infertility and ovarian aging phenotype caused by global germline deletion of Clpp is associated with somatic aging, and tested telomere length in young and aging mice gametes, gonads and somatic tissues."
The team found that impaired mtUPR caused by the lack of CLPP is associated with accelerated telomere shortening in both oocytes and somatic cells of aging mice. In addition, expression of several genes that maintain telomere integrity was decreased, and double-strand DNA breaks were increased in telomeric regions. Their results highlight how impaired mtUPR can affect telomere integrity and demonstrate a link between loss of mitochondrial protein hemostasis, infertility, and somatic aging.
"Our findings demonstrate how loss of mitochondrial protein homeostasis may accelerate telomere shortening in oocytes and somatic cells, and provide a link between reproductive and somatic aging."
Read the full paper: DOI: https://doi.org/10.18632/aging.205543
Corresponding Author: Emre Seli
/Public Release. This material from the originating organization/author(s) might be of the point-in-time nature, and edited for clarity, style and length. Mirage.News does not take institutional positions or sides, and all views, positions, and conclusions expressed herein are solely those of the author(s).View in full
here.
